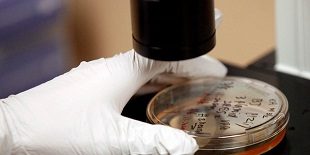

Kampala, Uganda | THE INDEPENDENT | Doctors under the Uganda Medical Association (UMA) have said there is so far no scientific study done in Uganda or abroad that has found a definitive gene responsible for homosexuality. This comes amidst concerns raised regarding whether gay or queer sexual expression occurs naturally as …
Read More »COMMENT: Say no to agricultural gene drives
Africans are now confronting a new and serious threat to our land, biodiversity, rights, and food supply COMMENT | MARIANN BASSEY-OROVWUJE | First, the agribusiness giants came to take our land and disrupt our food systems with synthetic pesticides, fertilisers, proprietary seeds, and genetically modified organisms (GMOs). Now, these firms’ hired …
Read More » The Independent Uganda: You get the Truth we Pay the Price
The Independent Uganda: You get the Truth we Pay the Price